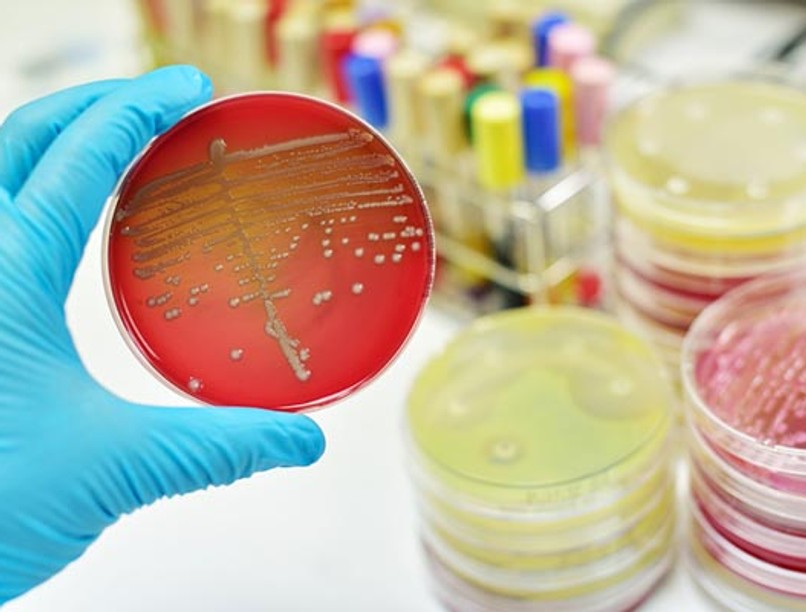
bakterium

Mit tehetünk azért, hogy megelőzzük az egyre terjedő MRSA- fertőzést?
Az MRSA megelőzéséhez tisztában kell lennünk azzal, hogyan is terjed ez a fertőzés. A Staphylococcus aureus tulajdonképpen mindenki szervezetében megtalálható, és meglehetősen sok emberben kimutatható a S. aureus gyógyszerrezisztens altípusa. A baktérium a bőr vagy a nyálkahártya sérülésein keresztül kerülhet a szervezetünkbe, és ott elszaporodhat, nehezen gyógyuló betegséget eredményezve.
Azok tehát, akiknek semmilyen sérülés nincs a bőrén, általában nincsenek veszélyben. Megfertőződhetünk egyrészt már beteg (vagy tünetek nélküli hordozó) személlyel való kontaktussal, de a kórokozó tárgyakon, felületeken is megmarad, és azokról is bejuthat a szervezetünkbe.
Kerüljük az érintkezést
A legjobb módszer tehát az MRSA fertőzés megelőzésére, ha kerüljük a fertőzöttekkel való kapcsolatot, fizikai érintkezést. Ez a már diagnosztizált betegek elkülönítését is jelentheti, de azt is, hogy igyekszünk megakadályozni, hogy a kórokozó a sebeken, bőrsérüléseken keresztül a testünkbe juthasson.
A horzsolásokat, vágásokat, sebeket alaposan és rendszeresen tisztítsuk meg és fedjük le (pl. ragtapasszal). Ez azért is különösen fontos, mert előfordulhat, hogy valaki csak hordozza a baktériumot, de az nem okoz nála betegséget, így pedig tüneteket sem.

Az MRSA gyanúját a laboratóriumi vizsgálat igazolják
Forrás: EgészségKalauz
Szintén tisztában kell lennünk azzal, hogy az MRSA "közvetetten" is a szervezetünkbe juthat, például valamilyen használati tárgyon keresztül. Lehetőleg ne osszunk meg másokkal személyes használati tárgyakat, például borotvát, törülközőket, fogkeféket.
Ügyeljünk a tisztaságra
Bár a túlzott tisztaság még többet is árthat, mint amennyit használ, a bakteriális fertőzések megelőzése érdekében érdemes fokozottan ügyelni nemcsak a személyes higiéniára, de a környezetünk tisztaságára is – különösen akkor, ha ismert MRSA-fertőzött él a közelünkben (pl. egy családtagunknál diagnosztizáltak a kórokozóval összefüggő betegséget), vagy ha különböző okok miatt a fertőzés fokozott rizikójával nézünk szembe (pl. krónikus egészségügyi problémák miatt). Az egyik legjobb módszer az MRSA-fertőzés elkerülésére a rendszeres és alapos kézmosás, meleg vízzel és szappannal.
Már említettük, hogy a használati tárgyakat lehetőleg ne osszuk meg másokkal, ez azonban nem mindig kivitelezhető, főleg akkor, ha éppen egy családtagunk lett beteg. A textíliákat, például ágyneműket vagy törülközőket magas hőfokon, más ruhaneműktől elkülönítve mossuk ki (ha lehetőségünk van rá, használjunk antibakteriális, fertőtlenítő hatású mosó- vagy öblítőszert); a gyakran megérintett tárgyakat, felületeket pedig rendszeresen, akár naponta tisztítsuk meg, töröljük át.
A konyhapult vagy a fürdőszobai felületek általában a tisztább felületek közé tartoznak, azonban arról sokan elfeledkeznek, hogy milyen gyakran érintik meg a villanykapcsolókat, a távirányítókat, a kilincseket, a számítógépek billentyűzetét vagy éppen a mobiltelefonokat.
Hallott már az antibiotikumokra rezisztens baktériumokról? Olvasson tovább!
Gondolkozzunk hosszabb távon is
Nem szabad figyelmen kívül hagynunk azt a tényt, hogy a gyógyszerrezisztens baktériumok megjelenése, illetve egyre elterjedtebbé válása komoly összefüggésben áll azzal, hogy sokan túlzásba viszik az antibiotikumok szedését, vagy éppen olyan betegségeket is antibiotikummal próbálnak gyógyítani, amelyeknél erre nincs szükség. Az MRSA esetében különösen körültekintően kell megválasztani azokat a gyógyszereket, melyekkel kezelik a fertőzést, éppen ezért nagyon fontos, hogy ne próbáljunk csak a házi módszerektől megoldást remélni, és MRSA gyanúja esetén minél hamarabb forduljunk orvoshoz!
Kövesse az Egészségkalauz cikkeit a Google Hírek-ben, a Facebook-on, az Instagramon vagy a X-en,Tiktok-on is!